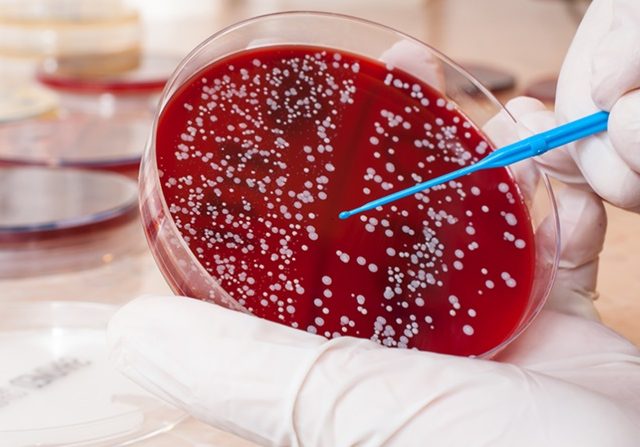

Ilustrasi kanker darah. Kanker darah atau blood cancer sendiri sebenarnya dibagi menjadi tiga yaitu leukemia, limfoma dan myeloma. Foto: Cancer center
PALU EKSPRES – Kanker memang masih menjadi salah satu penyakit mematikan di dunia. Kanker jugalah yang menyebabkan mantan Ibu Negara ke-6, Ani Yudhoyono, meninggal dunia pada umur 67 tahun.
Almarhumah melawan kanker darahnya selama 4 bulan di Singapura sejak 2 Februari 2019 dan berakhir pada tanggal 1 Juni 2019. Dalam penjelasannya kepada JawaPos.com, Dekan Fakultas Kedokteran Universitas Indonesia (FKUI) Prof. Dr.dr. H. Ari Fahrial Syam, SpPD-KGEH, MMB, ikut mengupas penyakit kanker darah yang diderita Ani Yudhoyono.
“Pada awal pemberitaan Pak SBY sempat memberikan keterangan pers bahwa ibu Ani menderita kanker darah. Kanker darah atau blood cancer sendiri sebenarnya dibagi menjadi tiga yaitu leukemia, limfoma dan myeloma,” jelas dr. Ari, Minggu (2/6/2019).
Ani Yudhoyono sendiri menderita leukemia. Leukemia menyerang sumsum tulang, limfoma menyerang kelenjar getah bening dan myeloma menyerang sel plasma. Leukemia bisa terjadi secara akut. Umur harapan hidup pasien leukemia kronik lebih baik dari pada leukemia akut.
Perjalanan Gejala Leukemia Gerogoti Pasien
Secara umum, pasien dengan leukemia kronik yang tetap minum obat, memiliki angka harapan hidup atau survival rate 5 tahun dengan capaian di atas 90 persen. Leukemia sendiri memang sering diderita pasien di atas usia 55 tahun dan pasien di bawah 20 tahun.
“Semakin tua usia semakin rendah umur harapan hidupnya,” ujarnya.
Pada leukemia, sel-sel kanker menyerang sumsum tulang sehingga menekan produksi sel darah merah dan trombosit. Leukemia dapat terjadi pada orang dewasa dan anak-anak.
“Secara umum pasien leukemia datang dengan anemia atau pucat karena hemoglobin yang rendah. Pasien juga bisa datang karena nyeri tulang. Seperti yang disampaikan oleh Pak SBY pada saat pemberitaan awal bahwa Ibu Ani dirawat karena adanya keluhan nyeri punggung,” jelasnya.
Selain itu, pasien dengan leukemia mengeluh lemas, cepat lelah, dan sakit kepala. Penderita leukemia juga mempunyai keluhan seperti demam, keringat malam dan seperti gejala sakit flu. Daya tahan tubuh yang menurun juga menyebabkan pasien rentan mengalami infeksi.
Perdarahan seperti mimisan atau gusi berdarah juga bisa dialami karena berhubungan dengan sistim pembekuan darah pasien. Leukemia yang menggerogoti tubuh juga membuat nafsu makan menurun sehingga mengalami penurunan berat badan.
“Pada pemeriksaan fisik dokter bisa saja menemukan, pembengkakan pada liver dan limpa,” ujarnya.
Diagnosis pasien leukemia ditegakkan berdasarkan anamnesis, pemeriksaan fisik, pemeriksaan darah dan pemeriksaan sumsum tulang. Hasil pemeriksaan tulang bisa menentukan jenis leukemia yang terjadi.
Penyebab Leukemia dan Pengobatannya
Secara umum penyebab kanker memang bermacam-macam, khusus untuk leukemia faktor genetik dan lingkungan menjadi risiko untuk terjadinya leukemia. Riwayat terkena radiasi atau zat kimia seperti benzene.
“Memang secara khusus tidak bisa ditentukan kenapa seseorang mengalami leukemia,” kata dr. Ari.
Sedangkan untuk pengobatan leukemia bisa dilakukan dengan kemoterapi. Selain itu, dilengkapi dengan kombinasi obat, biological therapy, targeted therapy serta transplantasi sumsum tulang.
“Almarhumah Ibu Ani Yudhoyono belum sempat menjalani transplantasi sumsum tulang. Ada hikmah yang dapat diambil dari perjalanan penyakit kanker almarhum Ibu Ani ini bahwa masyarakat harus peduli terhadap gangguan kesehatan yang terjadi dan memeriksaan kesehatan secara rutin apalagi ada riwayat kanker sebelumnya,” ujar dr. Ari.
Secara umum untuk menghindari dari berbagai penyakit khususnya penyakit kanker, masyarakat diminta hidup teratur, dengan menghindari gaya hidup yang tidak sehat seperti tidak merokok dan tidak minum alkohol. Hidup tidak ngoyo dan menghindari stres yang berlebihan apalagi jika sudah usia lanjut atau berumur di atas 60 tahun.
“Selamat jalan Ibu Ani Yudhoyono, semoga husnul khotimah dan keluarga yang ditinggalkan tabah dalam menerima cobaan ini,” tutupnya.
(mar/jpc)